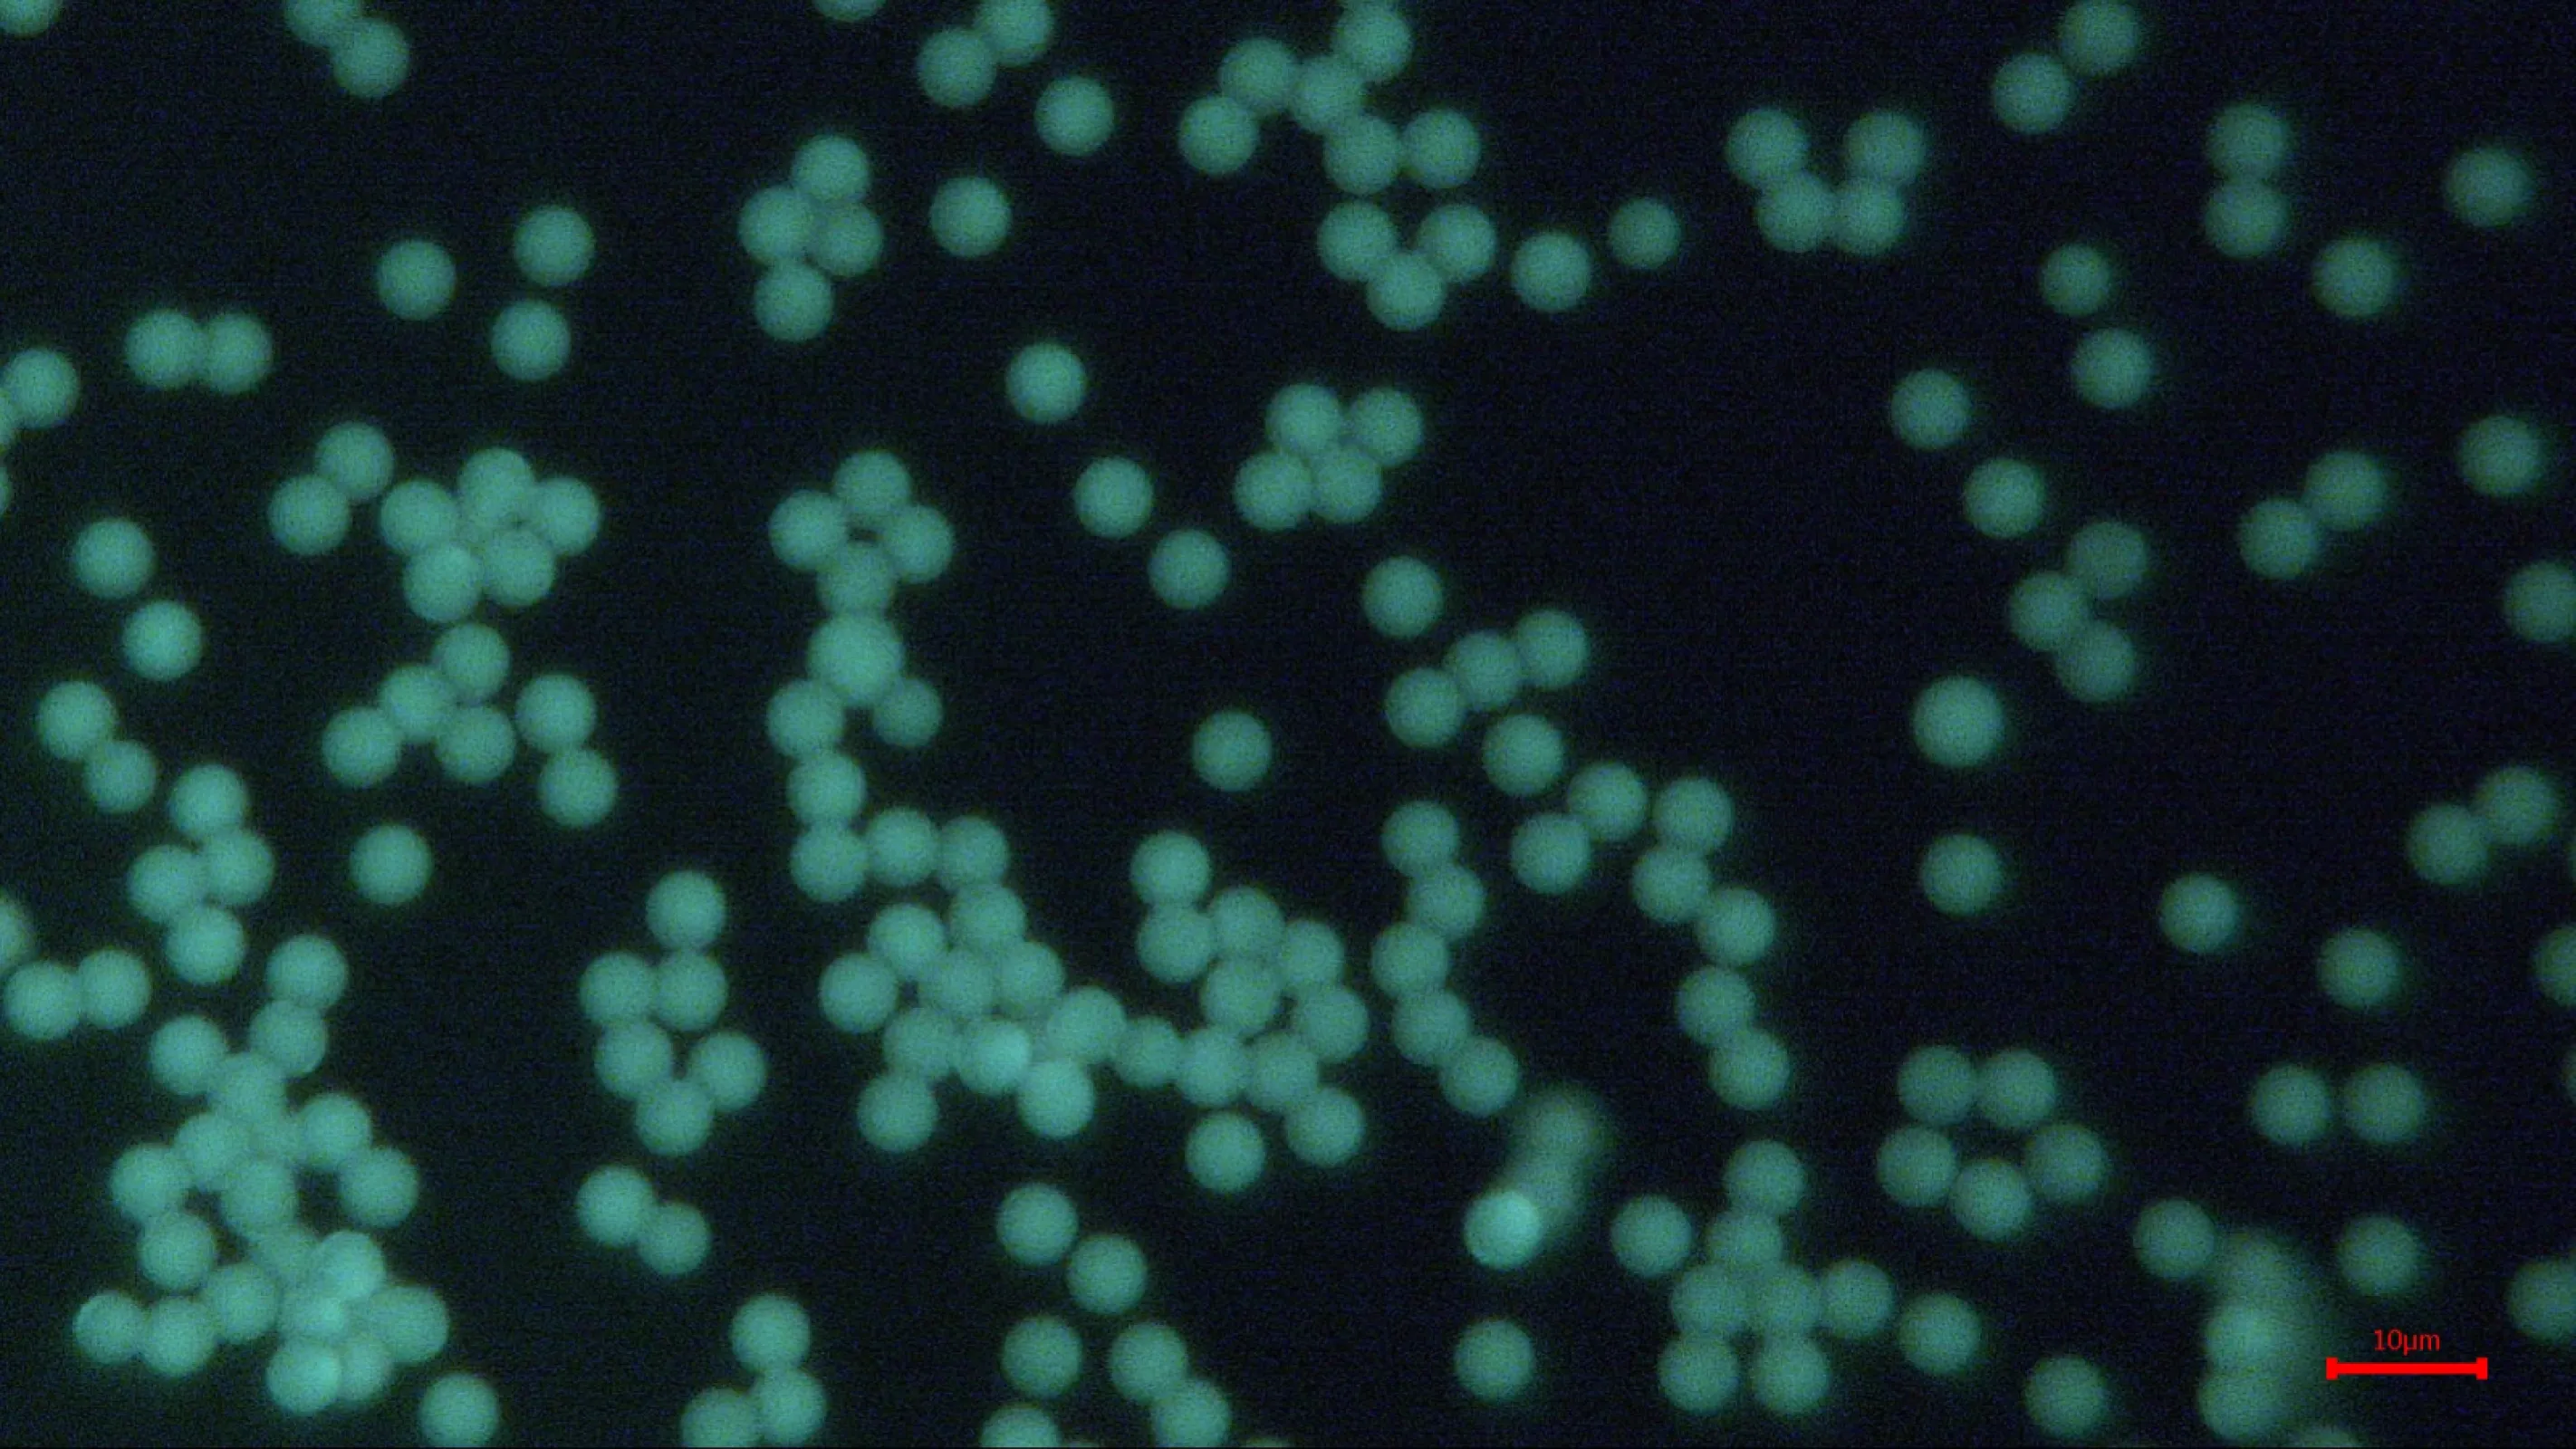
Fluorescent Polymer Microspheres

My German Pavilion
- Manage your personal profile here and enter your desired business contacts to German companies
- Keep an eye on the trade fairs, German exhibitors and products that are of interest to you
- Receive an e-mail notification on relevant upcoming German trade fair presentations